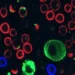

Por Chiara Lombardi — Em tempo de telas curtas e manchetes instantâneas, o cinema documental volta o olhar para uma instituição que sempre soube conjugar elegância e investigação: The New Yorker. “The New Yorker at 100”, dirigido por Marshall Curry e disponível na Netflix, traça um século de vida editorial, mostrando como uma revista semanal se transformou num verdadeiro espelho do nosso tempo.
Fundada em 21 de fevereiro de 1925, a revista nasceu com a promessa de ser “um reflexo em palavra e imagem da vida metropolitana”. A leitura desse documentário é um convite a entender como o jornalismo pode aliar erudição, rigor e senso crítico num mesmo gesto — algo que, na era da desinformação e das fake news, soa quase como um desafio ético e estético.
Curry percorre os marcos históricos e culturais que moldaram a revista: da consolidação da sua voz editorial às capas e cartoons que se tornaram ícones visuais. O filme lembra que The New Yorker não é só um produto editorial, mas uma incubadora de estilos literários — foi berço do que se chamaria depois de New Journalism. A revista publicou em capítulos obras que mudaram a linguagem do jornalismo, como A sangue frio de Truman Capote, os relatos monumentais de John Hersey sobre Hiroshima e até reflexões filosóficas como as de Hannah Arendt sobre a “banalidade do mal”.
O documentário também aponta para o cuidado artesanal que sempre distinguiu a redação: padrões de escrita elevados, fact-checking rigoroso e uma atenção ao aprofundamento que parece hoje quase um afeto antigo por vocações mais lentas. Essa prática fez de The New Yorker uma espécie de instituição artística, tão importante pela forma quanto pelo conteúdo — a revista como galeria, a página como quadro, o artigo como roteiro.
Entre as anedotas que atravessam o filme, destaca-se a máxima atribuída ao fundador Harold Ross: “A revista não é voltada para a dona de casa de Dubuque, Iowa”. Frase que, apesar da tradução cultural, virou mantra interno e deu origem à expressão italiana «la casalinga di Voghera» — um lembrete sobre o equilíbrio entre acessibilidade e exigência intelectual.
Mas o documentário não se limita a celebrar um legado: ele nos provoca a pensar o que significa produzir informação séria hoje. Em um cenário de cliques e virais, a narrativa de Curry funciona como um reframe da realidade jornalística, lembrando que a credibilidade se constrói com disciplina e estatura crítica. Ver The New Yorker em retrospectiva é ler a própria história cultural americana — um roteiro oculto de mudanças sociais, estéticas e políticas que reverbera internacionalmente.
Para quem ama jornalismo, literatura e as artes gráficas, o filme é um encontro necessário. Não é apenas uma celebração de um “milagre editorial”, mas uma reflexão sobre o ofício — um exercício de memória que nos força a perguntar: qual é hoje o papel de uma voz tão influente num mundo que prefere o ruído ao argumento?
Em termos simbólicos, o documentário funciona como um espelho que amplia pequenas fissuras do presente, mostrando como as revistas podem ser mais do que mídia: são mapas de entendimento, arquivos de sensibilidade e, às vezes, laboratórios de linguagem.